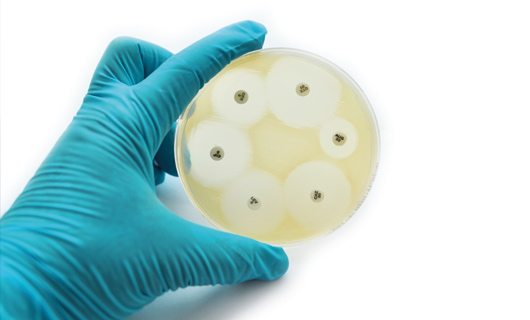
NETILMICINA: UNA CORRECTA ELECCIÓN

Nov 17, 2020 | eyevolution
Este contenido está reservado para usuarios registrados. Si no estás registrado, puedes hacerlo aquí. Tu solicitud será procesada y te enviaremos un correo con tus datos de acceso. Si ya estás registrado, puedes logarte aquí: Username or Email Contraseña Recuérdame...

Nov 11, 2020 | eyevolution
Este contenido está reservado para usuarios registrados. Si no estás registrado, puedes hacerlo aquí. Tu solicitud será procesada y te enviaremos un correo con tus datos de acceso. Si ya estás registrado, puedes logarte aquí: Username or Email Contraseña Recuérdame...

Oct 27, 2020 | eyevolution
METABOLÓMICA DE LA LÁGRIMA Y OJO SECO → 10 / 20 No hay duda, la medicina es una ciencia en continua evolución. Muestra de ello es el gran número de avances y descubrimientos acontecidos en el siglo pasado… y en el presente. De esta manera las ciencias ómicas han...

Oct 20, 2020 | eyevolution
COVID-19: MÁS QUE UNA INFECCIÓN RESPIRATORIA → 10 / 20 No hay duda, esta inacabable pandemia ha hecho mella en toda la población a nivel mundial. En el mejor de los casos solo ha cambiado la vida personal y profesional, sin tener que lamentar pérdidas irreparables....

Oct 14, 2020 | eyevolution
Este contenido está reservado para usuarios registrados. Si no estás registrado, puedes hacerlo aquí. Tu solicitud será procesada y te enviaremos un correo con tus datos de acceso. Si ya estás registrado, puedes logarte aquí: Username or Email Contraseña Recuérdame...

Oct 7, 2020 | eyevolution
Este contenido está reservado para usuarios registrados. Si no estás registrado, puedes hacerlo aquí. Tu solicitud será procesada y te enviaremos un correo con tus datos de acceso. Si ya estás registrado, puedes logarte aquí: Username or Email Contraseña Recuérdame...